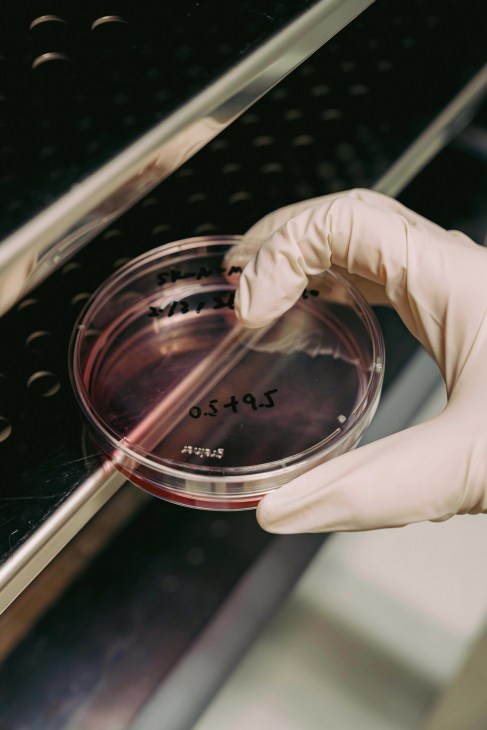
Chan testing in a lab

Explore
In historic Wan Chai, Lee Tung Avenue is a leafy boulevard filled with premium dining, design and boutique retail spots.
Wan Chai is one of Hong Kong’s earliest neighbourhoods – a place of backstreets, old tenements and multigenerational businesses. Threaded through it, Lee Tung Avenue offers a lively pathway: an unhurried strip that is made for browsing, grazing and experiencing the city in a softer light.
The avenue sits on the former Lee Tung Street, once known by locals as “wedding card street” for the printers and paper shops that operated there. After a major urban renewal project, completed in 2015, the area became a 200-metre shopping boulevard with a people-first focus. It’s a retail address, yes, but also a lesson in how design and good pacing can shape a neighbourhood for businesses and locals alike.
More than 6,500 sq m of the area is utilised for landscaping, with public open space across multiple levels and a vertical green wall that brings foliage into view from almost every angle. A number of 17-metre-tall michelia trees were transplanted from the old site, joined by flowering newcomers to complete the landscape design. Benches, sculptures and old-world gas lamps mix with stone, tile and colourful buildings to bring the heritage of Wan Chai to life once again.
Between the mix of designer boutiques and smaller shops, Lee Tung Avenue is lined with cafés and restaurants that encourage a leisurely pace. It is a place to stop for coffee, browse, then stay on into the evening for the seasonal light installations and festive decorations that lend the street a gentle glow.
leetungavenue.com.hk

Unwind
A relaxed seaside resort, The Fullerton Ocean Park Hotel offers a quiet escape from Hong Kong’s urban bustle.
Life immediately feels more spacious and relaxed on the south side of Hong Kong. Nowhere is that more apparent than at The Fullerton Ocean Park Hotel, whose expansive oceanfront setting features a refreshing sea breeze and a noticeably calmer register – with enough ease and space to suit families, too.
Days are infused with wellness and restoration, more relaxed than regimented. Start with a swim in the 60-metre-long infinity pool, where the waterline dissolves into the horizon and cabanas sit among lush greenery. Between laps, there’s always time for something cold from the pool bar.

If you prefer your wellness measured in steps rather than splashes, the gym opens early and, like most of the hotel, comes with sweeping sea views. The Fullerton’s sense of calm hasn’t happened by chance. The resort is the first in Hong Kong and mainland China to achieve Well v2 certification, a benchmark for how the building supports a healthier stay. It is felt in the bright, airy rooms and the calming design of public spaces, which naturally encourage guests to wind down.
Sustainability is similarly woven into the hotel’s outlook, shaping both its green features and its broader approach to hospitality. Coral-reef restoration, marine conservation and reduced plastic initiatives reinforce a connection to its coastline home. The result is a relaxing stay that feels more genuine and, in turn, more rewarding.
fullertonhotels.com


Inspire
Thanks to The Spirit of Hong Kong Awards, the city’s unsung heroes are being celebrated for their contributions.
Since 2013, Sino Group has jointly presented The Spirit of Hong Kong Awards – an annual celebration of people whose dedication helps shape the city. The initiative honours unsung heroes – those from near and far who have made Hong Kong home and whose efforts reflect its vibrant East-meets-West character.
Among this year’s winners is Edwin Chan, a genetics professor and the recipient of The Spirit of Innovation Award. Born and educated in Hong Kong before pursuing further studies abroad, Chan returned to the city in 2002 with a clear purpose: to build his research career at home and contribute to the local scientific community.

Over the past two decades, Chan has focused on understanding neurodegenerative diseases such as Huntington’s disease and ALS. His work, rooted in academic research, has since expanded into entrepreneurship. In recent years, Chan founded biotech start-up Rare Power with former students and collaborators, translating laboratory discoveries into potential treatments.
Chan’s decision to return to Hong Kong was shaped by a moment of realisation. While travelling home from the US early in his career, he happened upon a discarded newspaper and read that patients in the city were living with the very disease he was studying. “I thought I was just doing something in the lab,” he says. “But then I realised there are patients suffering here and what I do can eventually make an impact on their lives.” The recognition from The Spirit of Hong Kong Awards is therefore particularly meaningful. “Science should not be in a vacuum,” says Chan. “It has to have meaning.”
spiritofhk.scmp.com
